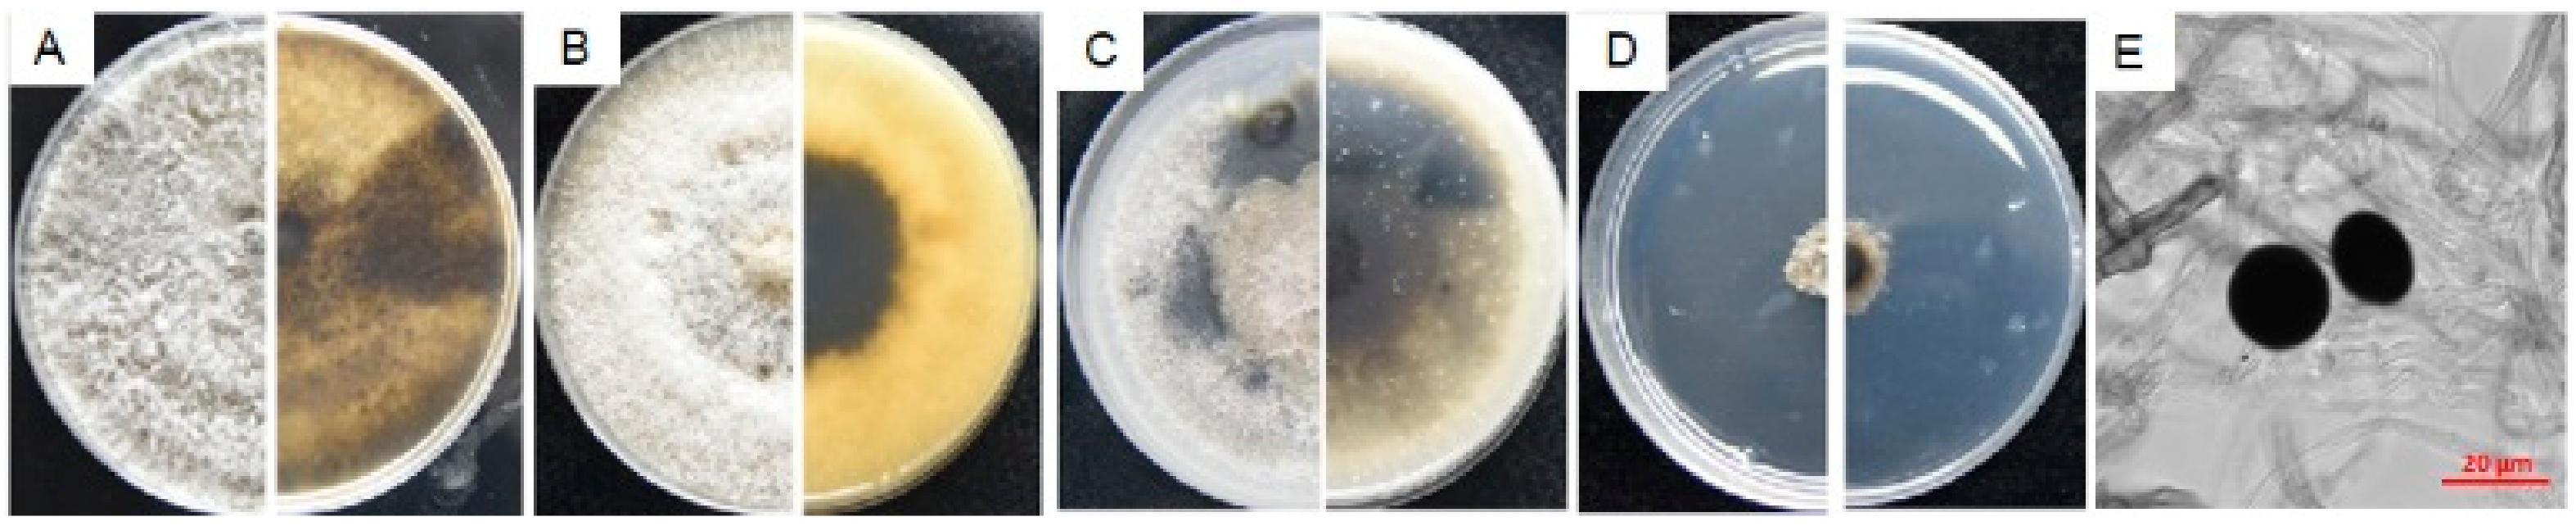
Microorganisms 08 00689 g007
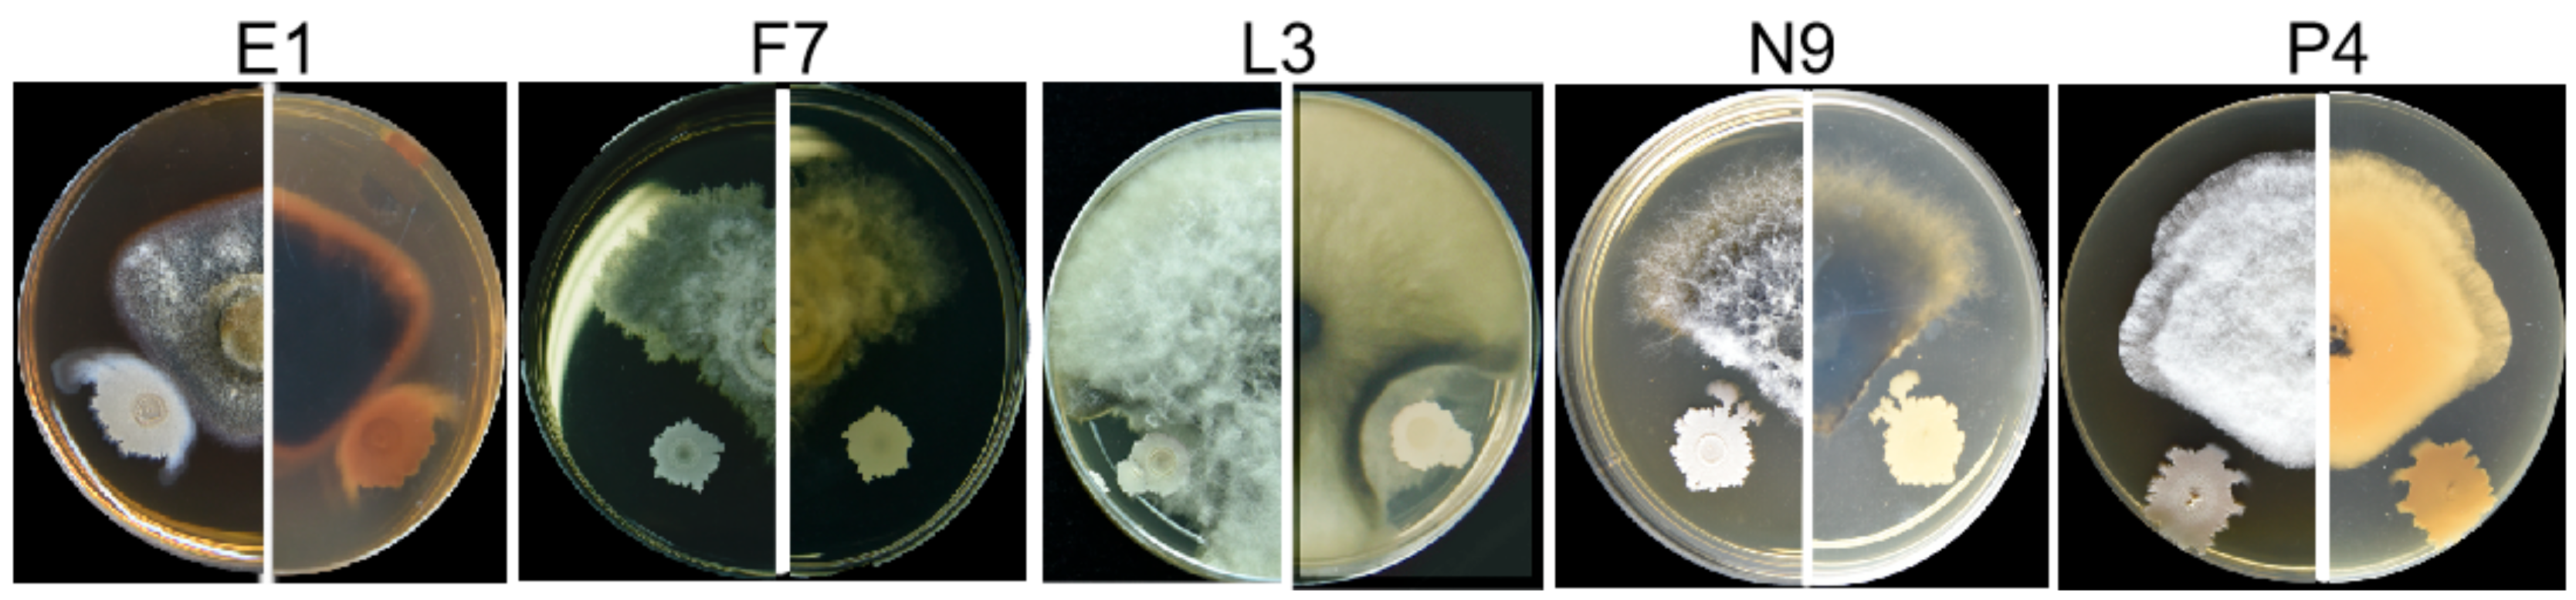
Microorganisms 08 00689 g009

Five Fungal Pathogens Are Responsible for Bayberry Twig Blight and Fungicides Were Screened for Disease Control
Abstract
:1. Introduction
2. Materials and Methods
2.1. Disease Investigation and Symptomatic Sample Collection
2.2. Isolation and Purification of Pathogens
2.3. Morphological Characterization
2.4. Multilocus Sequence Analysis (MLSA) and Phylogenetic Analysis
2.5. Pathogenicity Tests on Detached Leaves and Branches
2.6. Indoor Fungicide Screening
2.7. Tests of Antagonistic Bacteria against Pathogenic Fungi
2.8. Statistical Analysis
3. Results
3.1. Incidence and Symptoms of Bayberry Twig Blight in Jinzao Town
3.2. Pathogen Isolation and Identification
3.3. Fungal Isolates in E, F, L, N and P Groups Are Pathogenic
3.4. Characterization of Pathogens E1, F7, L3, N9 and P4
3.4.1. Characterization of E1
3.4.2. Characterization of F7
3.4.3. Characterization of L3
3.4.4. Characterization of N9
3.4.5. Characterization of P4
3.5. Prochloraz (Copper Salt) Is One of the Most Promising Fungicides That Could Control the Growth of the Five Pathogens
3.6. Bacillus Velezensis Strain 3–10 and Zeamines Can Be Used as Potential Antifungal Agents to Biocontrol the Bayberry Twig Blight
4. Discussion
5. Conclusions
Supplementary Materials
Author Contributions
Funding
Acknowledgments
Conflicts of Interest
References
- Kuang, K.; Cheng, S.; Li, P.; Lu, A. Flora reipublicae popularis sinicae (Vol. 21, Myricaceae, Juglandaceae, Betulaceae); Science Press: Beijing, China, 1979. (in Chinese) [Google Scholar]
- Ren, H.; Li, G.; Qi, X.; Fang, L.; Wang, H.; Wei, J.; Zhong, S. Identification and characterization of Pestalotiopsis spp. causing twig blight disease of bayberry (Myrica rubra Sieb. & Zucc) in China. Eur. J. Plant Pathol. 2013, 137, 451–461. [Google Scholar]
- Chen, F.; Lu, L.; Wang, D.; Wang, Y.; Ni, H.; Du, Z. Biological characterization and genetic diversity analysis of two species of Pestalotiopsis causing twig dieback of Myrica rubra. Eur. J. Plant Pathol. 2013, 136, 737–747. [Google Scholar] [CrossRef]
- He, G.; Xu, C.; He, F. Pathogen analysis and comprehensive control suggestions of bayberry twig blight disease. Zhejiang Citrus 2013, 30, 29–33. (in Chinese). [Google Scholar]
- Zheng, D.; Huang, W.; Lin, W.; Shen, H.; Zhang, Q.; Zheng, B. Investigation on reasons for Twig Blight of Myrica rubra and countermeasures in Jinzao Town, Shantou City. Guangdong For. Sci. Technol. 2015, 31, 102–105. (in Chinese). [Google Scholar]
- Qiu, Y.; Ren, H.; Wang, H.; Zheng, X.; Qi, X.; Wang, K.Q. Incidence investigation and pathogen inoculation of bayberry twig blight disease. Zhejiang Agric. Sci. 2011, 1, 98–100. (in Chinese). [Google Scholar]
- Chen, F.; Lu, L.; Ni, H.; Wang, Y.; Wang, Y.; Li, G. First report of Pestalotiopsis mangiferae and P. vismiae causing twig dieback of Myrica rubra in China. Plant Dis. 2012, 96, 588-588. [Google Scholar] [CrossRef]
- Lu, L.; Chen, G.; Hu, X.; Du, D.; Pu, Z.; Peng, A.; Cheng, B. Identification of Pestalotiopsis clavispora causing brown leaf spot on Chinese bayberry in China. Can. J. Plant Pathol. 2015, 37, 1–6. [Google Scholar] [CrossRef]
- Wang, D.; Du, Y.; Liu, Z.; Lin, J.; Zhong, J. Diagnosis and control of bayberry sudden dry blight. South China Fruits 2010, 39, 77–78. (in Chinese). [Google Scholar]
- Li, H.; Cao, R.; Ren, R.; Hu, Y. The symptom and pathogen of the bayberry (Myruca rybra) root rot. J. Zhejiang Agric. Univ. 1995, 21, 398–402. (in Chinese). [Google Scholar]
- Xu, C.; Zhang, H.; Zhou, Z.; Hu, T.; Wang, S.; Wang, Y.; Cao, K. Identification and distribution of Botryosphaeriaceae species associated with blueberry stem blight in China. Eur. J. Plant Pathol. 2015, 143, 737–752. [Google Scholar] [CrossRef]
- Roh, E.; Park, T.H.; Kim, M.I.; Lee, S.; Ryu, S.; Oh, C.S.; Rhee, S.; Kim, D.H.; Park, B.S.; Heu, S. Characterization of a new bacteriocin, Carocin D, from Pectobacterium carotovorum subsp. carotovorum Pcc21. Appl. Environ. Microbiol. 2010, 76, 7541–7549. [Google Scholar] [CrossRef] [Green Version]
- Zhou, J.; Zhang, H.; Wu, J.; Liu, Q.; Xi, P.; Lee, J.; Liao, J.; Jiang, Z.; Zhang, L. A novel multidomain polyketide synthase is essential for zeamine production and the virulence of Dickeya zeae. Mol. Plant-Microbe Interact. 2011, 24, 1156–1164. [Google Scholar] [CrossRef] [Green Version]
- Liao, L.; Cheng, Y.; Liu, S.; Zhou, J.; An, S.; Lv, M.; Chen, Y.; Gu, Y.; Chen, S.; Zhang, L. Production of novel antibiotics zeamines through optimizing Dickeya zeae fermentation conditions. PLoS ONE 2014, 9, e116047. [Google Scholar] [CrossRef] [PubMed]
- Liao, L.; Zhou, J.; Wang, H.; He, F.; Liu, S.; Jiang, Z.; Chen, S.; Zhang, L. Control of litchi downy blight by zeamines produced by Dickeya zeae. Sci. Rep. 2015, 5, 15719. [Google Scholar] [CrossRef] [PubMed] [Green Version]
- Innis, M.A.; Gelfand, D.H.; Sninsky, J.J.; White, T.J. PCR Protocols: A Guide to Methods and Applications; Academic Press: Cambridge, MA, USA, 2012. [Google Scholar]
- Glass, N.L.; Donaldson, G.C. Development of primer sets designed for use with the PCR to amplify conserved genes from filamentous ascomycetes. Appl. Environ. Microbiol. 1995, 61, 1323–1330. [Google Scholar] [CrossRef] [PubMed] [Green Version]
- Rehner, S.A. Primers for Elongation Factor 1-alpha (EF1-alpha). Available online: https://www.docin.com/p-1613748809.html. (accessed on 7 May 2020).
- Chen, Z.; Shen, H.; Xu, P.; Wang, Z.; Wu, C.; Li, B. Screening DNA barcode of three Pathogenic fungi within genus Botryosphaeria in apple. Hubei Agric. Sci. 2018, 57, 126–131. (in Chinese). [Google Scholar]
- Reyes-Chilpa, R.; Quiroz-Vázquez, R.; Jiménez-Estrada, M.; Navarro-Oca a, A.; Cassani-Hernández, J. Antifungal activity of selected plant secondary metabolites against Coriolus versicolor. J. Trop. For. Prod. 1997, 3, 110–113. [Google Scholar]
- Chen, Q.; Hou, L.; Duan, W.; Crous, P.; Cai, L. Didymellaceae revisited. Stud. Mycol. 2017, 87, 105–159. [Google Scholar] [CrossRef]
- De Oliveira, R.C.; Carnielli-Queiroz, L.; Correa, B. Epicoccum sorghinum in food: Occurrence, genetic aspects and tenuazonic acid production. Curr. Opin. Food Sci. 2018, 23, 44–48. [Google Scholar] [CrossRef]
- Phillips, A.; Alves, A.; Abdollahzadeh, J.; Slippers, B.; Wingfield, M.J.; Groenewald, J.; Crous, P.W. The Botryosphaeriaceae: Genera and species known from culture. Stud. Mycol. 2013, 76, 51–167. [Google Scholar] [CrossRef] [Green Version]
- Wang, M.; Liu, F.; Crous, P.; Cai, L. Phylogenetic reassessment of Nigrospora: Ubiquitous endophytes, plant and human pathogens. Pers. Mol. Phylogeny Evol. Fungi 2017, 39, 118. [Google Scholar] [CrossRef] [PubMed]
- Saccardo, P.A. Deuteromycetes, melanconiaceae, monochaetia. Sylloge Fungorum 1931, 25, 610. [Google Scholar]
- Steyaert, R. New and old species of Pestalotiopsis. Trans. Br. Mycol. Soc. 1953, 36, 81–89. [Google Scholar] [CrossRef]
- Wei, G.; Chen, Y. Further notes on congeners of Pestalotiopsis in China (II). J. Guangxi Agric. Univ. 1994, 2, 115–128. (in Chinese). [Google Scholar]
- Zhao, G.; Li, N. Thirty-four species of Pestalotiopsis in Yunnan. J. Northeast. For. Univ. 1995, 04, 21–27. (In Chinese) [Google Scholar]
- Yasuda, F.; Kobayashi, T.; Watanabe, H.; Izawa, H. Addition of Pestalotiopsis spp. to leaf spot pathogens of Japanese persimmon. J. Gen. Plant Pathol. 2003, 69, 29–32. [Google Scholar] [CrossRef]
- Maharachchikumbura, S.S.; Guo, L.-D.; Cai, L.; Chukeatirote, E.; Wu, W.P.; Sun, X.; Crous, P.W.; Bhat, D.J.; McKenzie, E.H.; Bahkali, A.H. A multi-locus backbone tree for Pestalotiopsis, with a polyphasic characterization of 14 new species. Fungal Divers. 2012, 56, 95–129. [Google Scholar] [CrossRef] [Green Version]
- Guba, E.F. Monograph of Monochaetia and Pestalotia; Harvard University Press: Cambridge, MA, USA, 1961; pp. 184–233. [Google Scholar]
- Boerema, G.H. Phoma Identification Manual: Differentiation of Specific and Infra-Specific Taxa in Culture; CABI Publishing: Wallingford, UK, 2004. [Google Scholar]
- Do Amaral, A.; De Carli, M.; Barbosa Neto, J.; Dal Soglio, F. Phoma sorghina, a new pathogen associated with phaeosphaeria leaf spot on maize in Brazil. Plant Pathol. 2004, 53, 259-259. [Google Scholar] [CrossRef]
- Perelló, A.E.; Moreno, M.V. First report of Phoma sorghina (Sacc.) Boerema Dorenbosch & van Kest on wheat leaves (Triticum aestivum L.) in Argentina. Mycopathologia 2005, 159, 75–78. [Google Scholar]
- Yuan, G.; Liao, T.; Tan, H.; Li, Q.; Lin, W. First report of leaf spot caused by Phoma sorghina on tobacco in China. Plant Dis. 2016, 100, 1790-1790. [Google Scholar] [CrossRef]
- Zhou, H.; Liu, P.; Qiu, S.; Wei, S.; Xia, K.; Gao, Q. Identity of Epicoccum sorghinum Causing Leaf Spot Disease of Bletilla striata in China. Plant Dis. 2018, 102, 1039-1039. [Google Scholar] [CrossRef]
- Milholland, R. Histopathology and pathogenicity of Botryosphaeria dothidea on blueberry stems. Phytopathology 1972, 62, 654–660. [Google Scholar] [CrossRef]
- Wright, A.; Harmon, P. Identification of species in the Botryosphaeriaceae family causing stem blight on southern highbush blueberry in Florida. Plant Dis. 2010, 94, 966–971. [Google Scholar] [CrossRef] [PubMed] [Green Version]
- Sharma, P.; Meena, P.D.; Chauhan, J.S. First Report of Nigrospora oryzae (Berk. & Broome) Petch Causing Stem Blight on Brassica juncea in India. J. Phytopathol. 2013, 161, 439–441. [Google Scholar]
- Liu, Y.; Tang, Q.; Fang, L. First report of Nigrospora sphaerica causing leaf blight on Camellia sinensis in China. Plant Dis. 2016, 100, 221. [Google Scholar] [CrossRef]
- Crous, P.W.; Summerell, B.A.; Swart, L.; Denman, S.; Taylor, J.; Bezuidenhout, C.; Palm, M.E.; Marincowitz, S.; Groenewald, J.Z. Fungal pathogens of Proteaceae. Pers. Mol. Phylogeny Evol. Fungi 2011, 27, 20–45. [Google Scholar] [CrossRef] [Green Version]
- Maharachchikumbura, S.S.; Chukeatirote, E.; Guo, L.-D.; Crous, P.W.; Mckenzie, E.H.; Hyde, K.D. Pestalotiopsis species associated with Camellia sinensis (tea). Mycotaxon 2013, 123, 47–61. [Google Scholar] [CrossRef]
- Maharachchikumbura, S.S.; Guo, L.-D.; Chukeatirote, E.; McKenzie, E.H.; Hyde, K.D. A destructive new disease of Syzygium samarangense in Thailand caused by the new species Pestalotiopsis samarangensis. Trop. Plant Pathol. 2013, 38, 227–235. [Google Scholar] [CrossRef] [Green Version]
- Maharachchikumbura, S.S.; Hyde, K.D.; Groenewald, J.Z.; Xu, J.; Crous, P.W. Pestalotiopsis revisited. Stud. Mycol. 2014, 79, 121–186. [Google Scholar] [CrossRef] [Green Version]
- Zhang, Y.; Maharachchikumbura, S.S.; Mckenzie, E.H.; Hyde, K.D. A novel species of Pestalotiopsis causing leaf spots of Trachycarpus fortunei. Cryptogam. Mycol. 2012, 33, 311–318. [Google Scholar] [CrossRef]
- Zhang, Y.; Maharachchikumbura, S.S.; Tian, Q.; Hyde, K.D. Pestalotiopsis species on ornamental plants in Yunnan Province, China. Sydowia 2013, 65, 113–128. [Google Scholar]
- Jiang, G.; He, S.; Tao, L.; Yue, H.; He, X. Identification of pathogen of macadamia leaf blight and selection of controlling pesticide. China Plant Prot. 2018, 8, 20–24. (in Chinese). [Google Scholar]
- Xue, D.; Shao, Z.; Li, B.; Wang, C.X. Indoor Fungicide screening for Pestalotiopsis clavispora of blueberry. Shandong Agric. Sci. 2018, 50, 115–118. (in Chinese). [Google Scholar]
- Sollepura Boregowda, R.; Murali, N.; C Udayashankar, A.; R Niranjana, S.; S Lund, O.; S Prakash, H. Antifungal Activity of Eclipta alba Metabolites against Sorghum Pathogens. Plants 2019, 8, 72. [Google Scholar] [CrossRef] [PubMed] [Green Version]
- Xu, C.; Chi, F.; Ji, Z.; Dong, Q.; Zhang, J.; Wang, N.; Cao, K.; Zhou, Z. Determination of virulence of 5 fungicides on Neofusicoccum parvum of blueberry twig blight disease. China fruits 2016, 3, 42–46. (in Chinese). [Google Scholar]
- Liu, S.; Hu, Q.; Yang, Y.; Li, P.; Ma, H.; Shi, J. Effects of culture conditions and fungicides on growth of Lasiodiplodia theobromae causing maize ear rot. Chin. J. Trop. Crops 2018, 39, 1611–1617. (in Chinese). [Google Scholar]
- Li, X.; Fu, H.; Li, H. Biological characteristics and fungicides screening of Nigrospora oryzae. J. Changjiang Veg. 2016, 6, 80–84. (in Chinese). [Google Scholar]

| Cultivar | Origin | Investigated Trees | Diseased Trees | Incidence (%) |
|---|---|---|---|---|
| Dongkui | Zhejiang | 100 | 95 | 95 |
| Fujian Dahong | Fujian | 60 | 48 | 80 |
| Yingsi | Zhejiang | 40 | 32 | 80 |
| Wusu | Guangdong | 80 | 12 | 15 |
| Aodi Wusu | Guangdong | 40 | 12 | 30 |
| Qingdi | Guangdong | 240 | 62 | 26 |
| Shanmei | Guangdong | 40 | 13 | 33 |
| Taxonomy | Isolate | Orchard | Tree | Cultivar | Tissue |
|---|---|---|---|---|---|
| Colletotrichum gloeosporioides | C1–C3 | Limin | A | Fujian Dahong | Leaf |
| C4–C6 | B | Yingsi | Leaf | ||
| C7, C8 | Caisong Peng | I | Fujian Dahong | Leaf | |
| C9 | II | Yingsi | Leaf | ||
| C10 | III | Dongkui | Leaf scar | ||
| Epicoccum sorghinum | E1 | Caisong Peng | II | Yingsi | Petiole base |
| Neofusicoccum parvum | F1, F2 | Limin | B | Yingsi | Leaf |
| F3 | Interior branch | ||||
| F4, F5 | Caisong Peng | I | Fujian Dahong | Leaf | |
| F6, F7 | III | Dongkui | Leaf scar | ||
| F8 | Petiole base | ||||
| Lasiodiplodia theobromae | L1 | Caisong Peng | I | Fujian Dahong | Leaf |
| L2 | Leaf scar | ||||
| L3 | Interior branch | ||||
| L4, L5 | II | Yingsi | Interior branch | ||
| L6 | Petiole base | ||||
| Nigrospora oryzae | N1 | Limin | A | Fujian Dahong | Leaf |
| N2 | Caisong Peng | II | Yingsi | Leaf | |
| N3 | III | Dongkui | Leaf | ||
| N4, N5 | Leaf scar | ||||
| N6, N7 | Interior branch | ||||
| N8, N9 | Petiole base | ||||
| Pestalotiopsis sp. | P1, P2 | Limin | C | Dongkui | Interior branch |
| P3, P4 | Caisong Peng | II | Yingsi | leaf | |
| P5 | Interior branch | ||||
| P6–P8 | III | Dongkui | Leaf scar | ||
| P9 | Interior branch | ||||
| P10–P14 | Leaf scar | ||||
| Cytospora tibouchinae | U1 | Limin | B | Yingsi | Interior branch |
| V1, V2 | C | Dongkui | Interior branch | ||
| V3 | D | Qingdi | Interior branch |
| Characteristics | Species | |||||
|---|---|---|---|---|---|---|
| P. myricae | P. conigena | P. albomaculans | P. crassiuscula | P. gracilis | P. versicolor | |
| Strain | P4 | - | - | Type strain | Type strain | Type strain |
| Length of conidia (μm) | 17.6–26.4 | 16.9–22.5 | 15–21.5 | 20–28 | 19–23 | 18–27 |
| Width of conidia (μm) | 3.7–6.9 | 7.3–8.1 | 6–7 | 7.5–9.0 | 6–7 | 6.5–10 |
| Color of median cells | Concolorous, dark brown to olivaceous | Versicolorous | Versicolorous | Concolorous, brown | Versicolorous | Versicolorous |
| Length of middle cells (μm) | 9.9–17.4 | 11.7–18.2 | 12.5–15 | 14–18 | - | 12–19 |
| Number of apical appendages | 2–4, mostly 2 | 2–4, mostly 3 | 3 | 3 | - | 2–3, rarely 4 |
| Number of basal appendages | 1–2, mostly 1 | 1 | 1 | 1 | 1 | 1 |
| Length of apical appendages (μm) | 18–40.2 | 18.2–26.1 | 10.5–24 | 10–23 | 10–26 | 12–33 |
| Length of basal appendages (μm) | 3.1–5.0 | 3.0–5.2 | 5.0–8.75 | 2.5–5.0 | - | 2–8 |
| Reference | This study | [28] | [27] | [31] | [25] | [26] |
| Fungicide | EC50 (mg/L) | ||||
|---|---|---|---|---|---|
| E1 | F7 | L3 | N9 | P4 | |
| Pyraclostrobin | 0.2738 ± 0.0082 | 0.0161 ± 0.0018 | - | 0.0222 ± 0.0007 | 0.0088 ± 0.0002 |
| Mancozeb | - | - | - | - | - |
| Prochloraz (copper salt) | 1.2396 ± 0.0747 | 0.0037 ± 0.0004 | 0.1585 ± 0.0091 | 0.0004 ± 0.0001 | 0.0692 ± 0.0022 |
| 15% Difenoconazole + 15% Propiconazole | - | 0.0456 ± 0.0029 | 0.4404 ± 0.1073 | 0.0010 ± 0.0001 | - |
| Iprodione | - | 0.2925 ± 0.0135 | 0.2703 ± 0.0141 | - | - |
| Thiophanate-Methyl | - | - | - | - | - |
| Tebuconazole | - | 0.0528 ± 0.0014 | 0.3753 ± 0.0139 | - | - |
| Difenoconazole | 0.2628 ± 0.0139 | 0.0460 ± 0.0020 | - | 0.0132 ± 0.0006 | - |
| Azoxystrobin | - | - | - | 0.0001 ± 0.0000 | 0.0422 ± 0.0007 |
| Chlorothalonil | - | 0.3825 ± 0.0077 | - | 1.8991 ± 0.1375 | |
| Myclobutanil | - | 0.1320 ± 0.0051 | 0.6518 ± 0.0481 | 0.0531 ± 0.0006 | - |
| Matrine | - | - | - | - | - |
| Boscalid | 0.1548 ± 0.0030 | - | - | - | - |
| Hymexazol | - | - | - | - | - |
| Dithianon | - | - | - | - | - |
| Carbendazim | - | - | - | - | - |
| Pathogen | Percentage of EC1 Supernatant in PDA Plate (%) | Percentage of Inhibition (% ± SE) | Results of Multiple Comparisons (α = 0.05) |
|---|---|---|---|
| P4 | 1 | 53.5 ± 0.36 | c |
| 5 | 70.7 ± 0.60 | b | |
| 10 | 94.02 ± 0.37 | a | |
| N9 | 1 | 71.75 ± 1.6 | c |
| 5 | 95.26 ± 0.96 | b | |
| 10 | 100.00 ± 0.00 | a | |
| F7 | 1 | 55.77 ± 1.77 | c |
| 5 | 86.68 ± 0.66 | b | |
| 10 | 96.64 ± 1.11 | a | |
| L3 | 1 | 29.22 ± 0.63 | c |
| 5 | 72.19 ± 2.20 | b | |
| 10 | 88.83 ± 1.63 | a | |
| E1 | 1 | 31.11 ± 1.38 | c |
| 5 | 66.58 ± 1.06 | b | |
| 10 | 94.26 ± 0.38 | a |
© 2020 by the authors. Licensee MDPI, Basel, Switzerland. This article is an open access article distributed under the terms and conditions of the Creative Commons Attribution (CC BY) license (http://creativecommons.org/licenses/by/4.0/).
Share and Cite
Li, W.; Hu, M.; Xue, Y.; Li, Z.; Zhang, Y.; Zheng, D.; Lu, G.; Wang, J.; Zhou, J. Five Fungal Pathogens Are Responsible for Bayberry Twig Blight and Fungicides Were Screened for Disease Control. Microorganisms 2020, 8, 689. https://doi.org/10.3390/microorganisms8050689
Li W, Hu M, Xue Y, Li Z, Zhang Y, Zheng D, Lu G, Wang J, Zhou J. Five Fungal Pathogens Are Responsible for Bayberry Twig Blight and Fungicides Were Screened for Disease Control. Microorganisms. 2020; 8(5):689. https://doi.org/10.3390/microorganisms8050689
Chicago/Turabian StyleLi, Wenjun, Ming Hu, Yang Xue, Zhijun Li, Yanfei Zhang, Daoxu Zheng, Guangtao Lu, Junxia Wang, and Jianuan Zhou. 2020. "Five Fungal Pathogens Are Responsible for Bayberry Twig Blight and Fungicides Were Screened for Disease Control" Microorganisms 8, no. 5: 689. https://doi.org/10.3390/microorganisms8050689
APA StyleLi, W., Hu, M., Xue, Y., Li, Z., Zhang, Y., Zheng, D., Lu, G., Wang, J., & Zhou, J. (2020). Five Fungal Pathogens Are Responsible for Bayberry Twig Blight and Fungicides Were Screened for Disease Control. Microorganisms, 8(5), 689. https://doi.org/10.3390/microorganisms8050689





